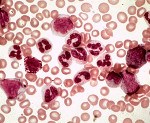

Другие названия и синонимы
Chronic myeloid leukemia.
МКБ-10 коды
|
|
Описание
Хронический миелобластный лейкоз (ХМЛ, хронический миелолейкоз, хронический миелоидный лейкоз) - форма лейкоза, которая характеризуется усиленным и нерегулируемым ростом преимущественно миелоидных клеток в костном мозге с их накоплением в крови. ХМЛ - гемопоэтическое клоновое заболевание, основным проявлением которого является пролиферация зрелых гранулоцитов (нейтрофилов, эозинофилов и базофилов) и их предшественников; вариант миелопролиферативного заболевания, ассоциированный с характерной хромосомной транслокацией (филадельфийской хромосомой). В настоящее время основным способом лечения хронического миелолейкоза является таргетная (целевая) терапия иматинибом и другими препаратами, значительно улучшившая показатели выживаемости.

Клиническая картина
Заболевание часто протекает бессимптомно, выявляясь при рутинном клиническом анализе крови. ХМЛ может проявляться недомоганием, субфебрильной лихорадкой, подагрой, повышенной восприимчивостью к инфекциям, анемией, тромбоцитопенией с кровоточивостью (хотя также может наблюдаться повышенное содержание тромбоцитов). Также отмечается спленомегалия.
ХМЛ часто разделяют на три фазы на основании клинических характеристик и лабораторных данных. В отсутствие лечения, ХМЛ обычно начинается с хронической фазы, в течение нескольких лет прогрессирует в фазу акселерации и, в конечном счёте, развивается бластный криз. Бластный криз - терминальная фаза ХМЛ, клинически подобная острому лейкозу. Одним из факторов прогресии от хронической фазы к бластному кризу является приобретение новых хромосомных аномалий (в дополнение к Филадельфийской хромосоме). Некоторые пациенты к моменту постановки диагноза могут находиться уже в фазе акселерации или в бластном кризе.
Около 85 % пациентов с ХМЛ к моменту постановки диагноза находятся в хронической фазе. В течение этой фазы клинические проявления обычно отсутствуют или имеются «лёгкие» симптомы, такие как недомогание или чувство переполнения живота. Продолжительность хронической фазы различна и зависит от того, насколько рано было диагностировано заболевание, а также от проведённого лечения. В конечном счёте, при отсутствии эффективного лечения, заболевание переходит в фазу акселерации.
Фаза акселерации.
Диагностические критерии перехода в фазу акселерации могут различаться: наиболее широко используются критерии, установленные исследователями онкологического центра Андерсона при Техасском университете, Сокалом с соавторами, а также Всемирной организацией здравоохранения. Критерии ВОЗ, вероятно, наиболее широко распространены, и отличают фазу акселлерации следующим:
• 10-19 % миелобластов в крови или костном мозге.
• >20 % базофилов в крови или костном мозге.
• <100,000 тромбоцитов, вне связи с терапией.
• >1,000,000, вне зависимости от терапии.
• Цитогенетическая эволюция с развитием новых аномалий в добавление к Филадельфийской хромосоме.
• Прогрессирование спленомегалии или увеличение числа лейкоцитов, вне зависимости от терапии.
Фаза акселерации предполагается при наличии любого из указанных критериев. Фаза акселерации указывает на прогрессию заболевания и ожидаемый бластный криз.
Бластный криз.
Бластный криз - финальная стадия развития ХМЛ, протекающая подобно острому лейкозу, с быстрой прогрессией и непродолжительной выживаемостью. Бластный криз диагностируется на основе одного из следующих признаков у пациента с ХМЛ:
• >20 % миелобластов или лимфобластов в крови или костном мозге.
• Крупные группы бластов в костном мозге при биопсии.
• Развитие хлоромы (солидного фокуса лейкемии вне костного мозга).
Ассоциированные симптомы: Базофилия. Высокая температура тела. Изменение аппетита. Изменение веса. Истощение. Кристаллурия. Лейкоцитоз. Ломота в суставах. Моноцитоз. Лихорадка. Недомогание. Нейтрофилез. Общая потливость. Потеря веса. Общая слабость. Тромбоцитоз. Увеличение СОЭ. Эозинофилия.
ХМЛ часто разделяют на три фазы на основании клинических характеристик и лабораторных данных. В отсутствие лечения, ХМЛ обычно начинается с хронической фазы, в течение нескольких лет прогрессирует в фазу акселерации и, в конечном счёте, развивается бластный криз. Бластный криз - терминальная фаза ХМЛ, клинически подобная острому лейкозу. Одним из факторов прогресии от хронической фазы к бластному кризу является приобретение новых хромосомных аномалий (в дополнение к Филадельфийской хромосоме). Некоторые пациенты к моменту постановки диагноза могут находиться уже в фазе акселерации или в бластном кризе.
Около 85 % пациентов с ХМЛ к моменту постановки диагноза находятся в хронической фазе. В течение этой фазы клинические проявления обычно отсутствуют или имеются «лёгкие» симптомы, такие как недомогание или чувство переполнения живота. Продолжительность хронической фазы различна и зависит от того, насколько рано было диагностировано заболевание, а также от проведённого лечения. В конечном счёте, при отсутствии эффективного лечения, заболевание переходит в фазу акселерации.
Фаза акселерации.
Диагностические критерии перехода в фазу акселерации могут различаться: наиболее широко используются критерии, установленные исследователями онкологического центра Андерсона при Техасском университете, Сокалом с соавторами, а также Всемирной организацией здравоохранения. Критерии ВОЗ, вероятно, наиболее широко распространены, и отличают фазу акселлерации следующим:
• 10-19 % миелобластов в крови или костном мозге.
• >20 % базофилов в крови или костном мозге.
• <100,000 тромбоцитов, вне связи с терапией.
• >1,000,000, вне зависимости от терапии.
• Цитогенетическая эволюция с развитием новых аномалий в добавление к Филадельфийской хромосоме.
• Прогрессирование спленомегалии или увеличение числа лейкоцитов, вне зависимости от терапии.
Фаза акселерации предполагается при наличии любого из указанных критериев. Фаза акселерации указывает на прогрессию заболевания и ожидаемый бластный криз.
Бластный криз.
Бластный криз - финальная стадия развития ХМЛ, протекающая подобно острому лейкозу, с быстрой прогрессией и непродолжительной выживаемостью. Бластный криз диагностируется на основе одного из следующих признаков у пациента с ХМЛ:
• >20 % миелобластов или лимфобластов в крови или костном мозге.
• Крупные группы бластов в костном мозге при биопсии.
• Развитие хлоромы (солидного фокуса лейкемии вне костного мозга).
Ассоциированные симптомы: Базофилия. Высокая температура тела. Изменение аппетита. Изменение веса. Истощение. Кристаллурия. Лейкоцитоз. Ломота в суставах. Моноцитоз. Лихорадка. Недомогание. Нейтрофилез. Общая потливость. Потеря веса. Общая слабость. Тромбоцитоз. Увеличение СОЭ. Эозинофилия.
Дифференциальная диагностика
ХМЛ следует дифференцировать от лейкемоидной реакции, при которой мазок крови может имееть схожую картину.
Причины
ХМЛ стал первым злокачественным заболеванием с выявленной генетической аномалией, хромосомной транслокацией, которая проявляется патологической Филадельфийской хромосомой. Эта хромосомная патология получила своё название, так как была впервые открыта и описана в 1960 году учёными из Филадельфии, Пенсильвания, США: Питером Ноуеллом (Пенсильванский университет) и Дэвидом Хангерфордом (университет Темпл).
При этой транслокации, части из 9ой и 22ой хромосом меняются местами. В результате, к части вCR-гена из хромосомы 22 прикрепляется ABL-ген из хромосомы 9. Этот аномальный «слившийся» ген генерирует белок p210, или, иногда, p185. Так как abl имеет область, добавляющую фосфатную группу к тирозиновому остатку (тирозин-киназа), продукт аномального гена также является тирозин-киназой.
Белок вCR-ABL взаимодействует с частью клеточного рецептора к ИЛ-3 (CD123-антигеном). Транскрипция вCR-ABL работает непрерывно и не нуждается в активации другими белками. С другой стороны, сам вCR-ABL активирует белковый каскад, контролирующий клеточный цикл, ускоряя деление клеток. Более того, белок вCR-ABL подавляет репарацию ДНК, вызывая неустойчивость генома и делая клетку более восприимчивой к дальнейшим генетическим аномалиям. Активность вCR-ABL - патофизиологическая причина хронического миелолейкоза. С улучшением понимания природы вCR-ABL белка и его действия в качестве тирозин-киназы, была разработана таргетная (целевая) терапия, позволяющая специфически ингибировать активность вCR-ABL белка. Эти ингибиторы тирозин-киназы могут способствовать полной ремиссии ХМЛ, что ещё раз подтверждает ведущую роль bcr-abl в развитии заболевания.
При этой транслокации, части из 9ой и 22ой хромосом меняются местами. В результате, к части вCR-гена из хромосомы 22 прикрепляется ABL-ген из хромосомы 9. Этот аномальный «слившийся» ген генерирует белок p210, или, иногда, p185. Так как abl имеет область, добавляющую фосфатную группу к тирозиновому остатку (тирозин-киназа), продукт аномального гена также является тирозин-киназой.
Белок вCR-ABL взаимодействует с частью клеточного рецептора к ИЛ-3 (CD123-антигеном). Транскрипция вCR-ABL работает непрерывно и не нуждается в активации другими белками. С другой стороны, сам вCR-ABL активирует белковый каскад, контролирующий клеточный цикл, ускоряя деление клеток. Более того, белок вCR-ABL подавляет репарацию ДНК, вызывая неустойчивость генома и делая клетку более восприимчивой к дальнейшим генетическим аномалиям. Активность вCR-ABL - патофизиологическая причина хронического миелолейкоза. С улучшением понимания природы вCR-ABL белка и его действия в качестве тирозин-киназы, была разработана таргетная (целевая) терапия, позволяющая специфически ингибировать активность вCR-ABL белка. Эти ингибиторы тирозин-киназы могут способствовать полной ремиссии ХМЛ, что ещё раз подтверждает ведущую роль bcr-abl в развитии заболевания.
Лечение
Лечение при хроническом миелолейкозе начинают после установления диагноза и обычно проводят амбулаторно.
При отсутствии симптомов хронического миелолейкоза на фоне стабильного лейкоцитоза, не превышающего 40-50- 109/л, применяют гидроксимочевину или бусульфан до достижения содержания лейкоцитов в крови 20*109/л.
По мере прогрессирования хронического миелолейкоза показаны гидроксимочевина (гидрэа, литалир), а-ИФН. При значительной спленомегалии проводят облучение селезёнки.
При выраженной симптоматике хронического миелолейкоза используют комбинации препаратов, применяемых при острых лейкозах: винкристин и преднизолон, цитарабин (цитозар) и даунорубицин (рубомицина гидрохлорид). В начале терминальной стадии иногда эффективен митобронитол (миелобромол).
В настоящее время для терапии хронического миелолейкоза предложен новый препарат - блокатор мутантной тирозинкиназы (р210) - Гливека (STI-571). При бластном кризе ХМЛ и при Ph-позитивных ОЛЛ дозу увеличивают. Применение препарата приводит к полной ремиссии заболевания без эрадикации опухолевого клона.
Трансплантация стволовых клеток крови или красного костного мозга, проводимая больным моложе 50 лет в I стадии заболевания, в 70% случаев приводит к выздоровлению.
При отсутствии симптомов хронического миелолейкоза на фоне стабильного лейкоцитоза, не превышающего 40-50- 109/л, применяют гидроксимочевину или бусульфан до достижения содержания лейкоцитов в крови 20*109/л.
По мере прогрессирования хронического миелолейкоза показаны гидроксимочевина (гидрэа, литалир), а-ИФН. При значительной спленомегалии проводят облучение селезёнки.
При выраженной симптоматике хронического миелолейкоза используют комбинации препаратов, применяемых при острых лейкозах: винкристин и преднизолон, цитарабин (цитозар) и даунорубицин (рубомицина гидрохлорид). В начале терминальной стадии иногда эффективен митобронитол (миелобромол).
В настоящее время для терапии хронического миелолейкоза предложен новый препарат - блокатор мутантной тирозинкиназы (р210) - Гливека (STI-571). При бластном кризе ХМЛ и при Ph-позитивных ОЛЛ дозу увеличивают. Применение препарата приводит к полной ремиссии заболевания без эрадикации опухолевого клона.
Трансплантация стволовых клеток крови или красного костного мозга, проводимая больным моложе 50 лет в I стадии заболевания, в 70% случаев приводит к выздоровлению.
|
|
Связанные клинические рекомендации
Связанные стандарты мед. помощи
- Стандарт специализированной медицинской помощи после трансплантации аллогенного костного мозга (обследование и коррекция лечения)
- Стандарт специализированной медицинской помощи при донорстве аутологичного костного мозга
- Стандарт медицинской помощи больным с миелолейкозом и другими гемобластозами
- Стандарт медицинской помощи больным с хроническим миелолейкозом